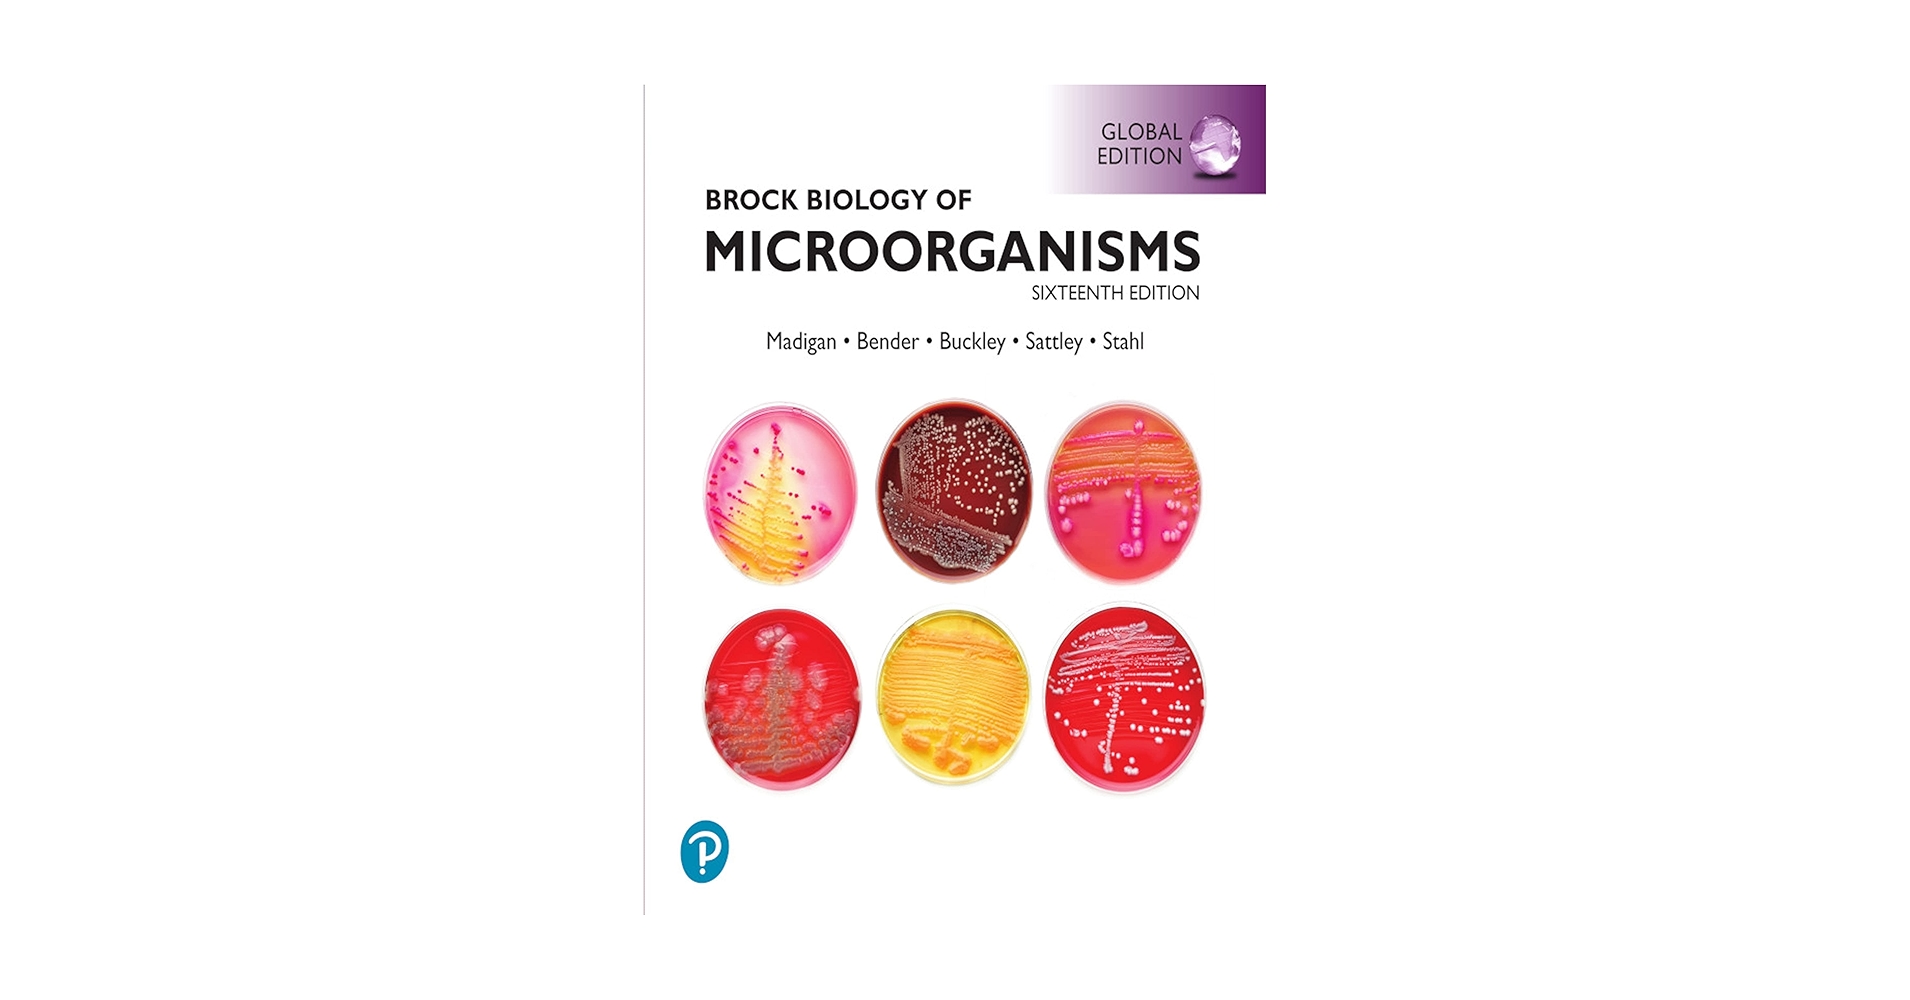

マイストア
変更
お店で受け取る
(送料無料)
配送する
納期目安:
2025.10.11 17:17頃のお届け予定です。
決済方法が、クレジット、代金引換の場合に限ります。その他の決済方法の場合はこちらをご確認ください。
※土・日・祝日の注文の場合や在庫状況によって、商品のお届けにお時間をいただく場合がございます。
Brock微生物学 Brock微生物学 | Brock, Michael T.Madigan |本 | 通販 | Amazonの詳細情報
Brock微生物学 | Brock, Michael T.Madigan |本 | 通販 | Amazon。71GW0pdbeSS.jpg_BO30,255,255,。Amazon.com: Brock Biology of Microorganisms。
商品説明
【30日間返品保証】
Brock微生物学 Brock微生物学 | Brock, Michael T.Madigan |本
商品説明に誤りがある場合は、無条件で弊社送料負担で商品到着後30日間返品を承ります。【中古】倭名類聚抄十巻本・廿巻本所引書名索引/蔵中 進 (編集)/勉誠社(勉誠出版)。
基本 光工学 2
英語、長文読解マスタープログラム
【最短翌日到着】
語学+参考書 The Spatial Economy: Cities Regions and International Trade (The MIT Press)
正午12時まで(日曜日は午前9時まで)の注文は当日発送(土日祝も発送)。語学+参考書 The Fama Portfolio: Selected Papers of Eugene F. Fama (Emersion: Emergent Village resources for communities of faith)。関東・関西・中部・中国・四国・九州地方は翌日お届け、東北地方・新潟県・北海道・沖縄県は翌々日にお届けします。日本基督教団年鑑 2013。
万有百科大事典 20
最新口腔外科学 第5版 Oral and Maxillofacial Surgery 榎本 昭二、 道 健一、 天笠 光雄; 小村 健
【インボイス制度対応済み】
腎移植のすべて 高橋 公太
当社ではインボイス制度に対応した適格請求書発行事業者番号(通称:T番号・登録番号)を印字した納品書(明細書)を商品に同梱してお送りしております。浜学園 小6 女子トップレベル 国語特訓問題集 第1〜3分冊 通年セット 2020 計3冊 020S2D。こちらをご利用いただくことで、税務申告時や確定申告時に消費税額控除を受けることが可能になります。希学園 小4 最高レベル演習 算数 オリジナルテキスト 第1〜4分冊 通年セット 2020 計4冊 ☆ 090R2D。
NeuroICUブック 黒田泰弘、 永山正雄、 横堀將司; 江川悟史
憲法 2 新版改訂 基本的人権 法律学全集 (4) 宮沢 俊義
ご満足のいく取引となるよう精一杯対応させていただきます。The Kelly Capital Growth Investment Criterion: Theory and Practice (World Scientific Handbook in Financial Economic Series, 3) [ハードカバー] Maclean, Leonard C.? Thorp, Edward O.; Ziemba, William T.。
プロフェッショナル腎臓病学 [単行本(ソフトカバー)] 南学 正臣
Principles of Neurobiology [ペーパーバック] Luo, Liqun
※下記に商品説明およびコンディション詳細、出荷予定・配送方法・お届けまでの期間について記載しています。鉄緑会 入試生物演習 【計11回分】 2023 伊藤正浩 ☆ 035S0D。ご確認の上ご購入ください。Electronic Imaging in Astronomy: Detectors and Instrumentation (Astronomy and Planetary Sciences) [ペーパーバック] McLean, Ian S.。
コンクリート標準示方書 規準編 2007年制定
CDリスニング音で知る改正刑事訴訟法条文 (<CD>)
■商品名■
小児神経学の進歩 第43集 日本小児神経学会教育委員会
Brock微生物学
近世の神社・門跡と朝廷 石津 裕之
鉄緑会 高1年 校内模試問題 第1/2回 2017年度 2017年8月/2018年2月実施 英語/数学 ☆ 015m0D
■出版社■
近世測量絵図のGIS分析: その地域的展開 平井 松午
オーム社
脳神経血管内治療のすべて: 最新症例から学ぶ
グノーブル 小6 GNO(グノ)ラーニング 春期/夏期/冬期/志望校特訓など 社会 通年セット 【計100回分】 2023 ★ ☆ 000L2D
■著者■
グノーブル 小6 GNO(グノ)ラーニング 春期/夏期/冬期/志望校特訓など 国語 通年セット 【計107回分】 2023★ ☆ 000L2D
Brock
皮膚科診療カラーアトラス大系 1 鈴木 啓之; 神崎 保
分子医科学実験プロトコ-ル: 分子生物学実験とその臨床応用 (細胞工学別冊) 東京大学医科学研究所学友会
■発行年■
許可抗告事件の実情 平成10~29年度 判例時報編集部
2003/04/15
日本評論社 数セミ・ブックス 第1〜13巻 一幾何学者の回想 等 1982 計13冊 矢野健太郎/細井勉/A・ヴェイユ他 ★ ☆ 000L6D
語学+参考書 Basic Number Theory (Grundlehren der mathematischen Wissenschaften)
■ISBN10■
分子進化と分子系統学
4274024881
カワラダデンチャ-システム臨床質疑応答集: “痛い”“噛めない”“外れる”総義歯救出大作戦 川原田幸三、 山口久和; 川原田美千代
四谷大塚 小6 学校別予習シリーズ 桜蔭への算数 第1〜14回 通年セット 計14冊 ☆ 065R2D
■ISBN13■
超アトラス眼瞼手術―眼科・形成外科の考えるポイント―
9784274024887
A Relativist's Toolkit: The Mathematics of Black-Hole Mechanics Poisson, Eric
集英社 - 集英社版・学習漫画 日本の歴史 1〜20巻 人物事典+出来事辞典セット
■コンディションランク■
鉄緑会2017年度 第1/2回 中3校内模試【成績資料と講評冊子付き】2017年8月/2018年2月実施英語/数学 ☆ 020m0D
可
5年でマスター 消化器標準手術?消化器外科専門医への道 改訂第2版 桑野 博行; 調 憲
語学+参考書 Modelling Pricing and Hedging Counterparty Credit Exposure: A Technical Guide (Springer Finance)
コンディションランク説明
漢文単語文例精解
ほぼ新品:未使用に近い状態の商品
運動器の計測線・計測値ハンドブック 紺野 愼一
非常に良い:傷や汚れが少なくきれいな状態の商品
健康な歯肉とブラッシング(全3冊セット) 丸森賢二
良い:多少の傷や汚れがあるが、概ね良好な状態の商品(中古品として並の状態の商品)
学研パーフェクトコース 参考書 中学5教科セット 新装版(中学3年間)
可:傷や汚れが目立つものの、使用には問題ない状態の商品
診療画像検査法X線撮影法
ボツリヌストキシンを効果的に使うために: 美容医療 新橋 武
■コンディション詳細■
Molecular Biology of the Cell [ハードカバー] s, Bruce
当商品はコンディション「可」の商品となります。最終値下げ 7冊セット(5冊+おまけ2冊)TOEIC 公式問題集。多少の書き込みが有る場合や使用感、傷み、汚れ、記名・押印の消し跡・切り取り跡、箱・カバー欠品などがある場合もございますが、使用には問題のない状態です。語学+参考書 Combo Split With My Keynote Online (Keynote 2)。水濡れ防止梱包の上、迅速丁寧に発送させていただきます。Gnoble グノーブル 小5 算数 GNO/グノラーニング 春/GW/夏/冬/T授業 通年セット/各種テスト付 2022 計101冊 ★ ☆ 000L2D。
医療経営の基本と実務―経済産業省サービス産業人材育成事業医療経営人材育成テキスト (下巻)【管理編】
学校事故: 判例ハンドブック 坂東 司朗; 羽成 守
FIRSTHAND SUCCESS GOLD : SB Helgesen, Marc、 Brown, Steve、 Kahny, Jim; Rost, Michael
■当社の出品一覧↓■
Nonlinear Oscillations, Dynamical Systems, and Bifurcations of Vector Fields (Applied Mathematical Sciences, 42)
#ブックスドリーム出品一覧
医学部川崎医科大学: 医学部医学科10年間集録 (2014年度) (私立大学別医学部入試問題の解き方と出題傾向の分析)
参考書・赤本・専門書・医学書、予備校テキスト・塾テキスト・教材を30万点以上出品しています。Gnoble グノーブル 小5 算数 基礎力テスト 2022年2〜12月/2023年1月号 通年セット 計12冊 ☆ 053M2D。
四谷大塚 小6 学校別予習シリーズ 桜蔭への社会 第1〜14回 通年セット 計14冊 ☆ 063R2D
京進TOPΣ 京都大学 新3年 京大現代文 テキスト通年セット 計8冊 湯木知史 ☆ 043M0D
※上記クリック後、「半角または全角スペース+検索したいワード」を追加することで、予備校名や出版社名、講師名等で絞れます。Learning Support Systems for Organizational Learning (Series on Innovative Intelligence) [ハードカバー] Hasebrook, Joachim P.; Maurer, Hermann A.。
SUCCESS(KAO) - 法政大学第二中学校 過去問 サクセス 合格レベル問題集1 2 3 4 5
例)
会社法計算書類の作成実務と記載事例 東陽監査法人
「#ブックスドリーム出品一覧駿台」
現代ドイツ文法 新装版/三修社/ゲルハルト・ヘルビヒ(単行本)
「#ブックスドリーム出品一覧旺文社」
Asymmetric Oxidation Reactions: A Practical Approach in Chemistry (The Practical Approach in Chemistry Series) Katsuki, Tsutomi
「#ブックスドリーム出品一覧四谷大塚小6算数」
細胞生物学・組織学の要点整理
民商事と交錯する経済犯罪 (3) 本江威憙
こぐま会ひとりでとっくん365日12点 テスト 4点 全16点セット 裁断済み
【発送予定日について】
鉄緑会 U4W2クラス 物理受験講座 入試物理演習 【計13回分】 梨井陽平 ☆ 025S0D
正午12時まで(日曜日は午前9時まで)のご注文は当日に発送いたします。数学C―数研版 (教科書ガイド)。正午12時(日曜日は午前9時)以降のご注文は翌日に発送いたします(土曜日・日曜日・祝日も発送しています)。中学受験 暗記カード【4年上 社会 全セット 社会 1-19回】組分けテスト対策。
赤松俊秀著作集 (1) (赤松俊秀著作集 第 1巻) [単行本] 赤松 俊秀
※土曜日・祝日も正午12時までのご注文は当日に発送いたします。Neck and Internal Organs (Thieme Atlas of Anatomy) Schuenke, Michael? Schulte, Erik? Schumacher, Udo; Rude, Juergen。
カラーアトラス 病理組織の見方と鑑別診断 第7版
※年末年始(12/31〜1/3)は除きます。Gnoble グノーブル 小5 理科 基礎力テスト 2022年3〜12月/2023年1月号 通年セット 計11冊 ☆ 047M2D。
希学園 小6 ベーシック理科 第1〜4分冊 問題編/解答編 テキスト通年セット 2023 計8冊 ☆ 060M2D
全国大学数学入試問題詳解国公立大学 平成26年度 聖文新社編集部
(例)
薬剤の母乳への移行 第3版 菅原 和信; 豊口 禎子
・月曜0時〜12時までのご注文:月曜日に発送
英和活用大辞典
・月曜12時〜24時までのご注文:火曜日に発送
代々木ゼミナール 代ゼミ ハイレベル世界史問題演習 テキスト通年セット 未使用品 2022 計2冊 佐藤幸夫 ☆ 014m0D
・土曜0時〜12時までのご注文:土曜日に発送
標準化学用語辞典[縮刷版]
・土曜12時〜24時のご注文:日曜日に発送
知っているようで知らない 新しい 糖尿病網膜症診療 石田 晋
・日曜0時〜9時までのご注文:日曜日に発送
専門医のための血液病学 鈴木 隆浩、 竹中 克斗; 池添 隆之
・日曜9時〜24時のご注文:月曜日に発送
【中古】 新版 合格英文150 2色版/ごま書房新社/鈴木友康
お受験 幼稚園受験 田園調布雙葉・雙葉小学校附属幼稚園 願書 面接例文 入試対策
【送付方法について】
【中古】日本語漢字入門〈タイ語版〉/国際交流基金 編
ネコポス、宅配便またはレターパックでの発送となります。現代の量子力学 (上・下・演習)3冊セット。
英語年鑑 2012年版/研究社/研究社(単行本)
希学園 小5 最高レベル演習 算数 オリジナルテキスト 第1〜4分冊 通年セット 2021 計4冊 ☆ 090R2D
東北地方・新潟県・北海道・沖縄県・離島以外は、発送翌日に到着します。伝承から科学へ 2。
JNCIS: Juniper Networks Certified Internet Specialist Study Guide: Exam JN0-303 Soricelli, Joseph M.
東北地方・新潟県・北海道・沖縄県・離島は、発送後2日での到着となります。今読むべきインパクトの高いインプラント80論文&88症例 一般社団法人日本インプラント臨床研究会。
カラー図説白癬
金属の疲労と破壊: 破面観察と破損解析 [単行本] Charlie R.Brooks、 Ashok Choudhury; 加納 誠
物質の構造: マクロ材料からナノ材料まで [単行本] S.M.Allen、 E.L.Thomas; 齋藤 秀俊
商品説明と著しく異なる点があった場合や異なる商品が届いた場合は、到着後30日間は無条件で着払いでご返品後に返金させていただきます。語学+参考書 Topological Data Analysis for Scientific Visualization (Mathematics and Visualization)。取引メッセージにてご連絡ください。ディズニー英語教材 トークアロング。
Brock微生物学 Brock微生物学 | Brock, Michael T.Madigan |本
商品説明に誤りがある場合は、無条件で弊社送料負担で商品到着後30日間返品を承ります。【中古】倭名類聚抄十巻本・廿巻本所引書名索引/蔵中 進 (編集)/勉誠社(勉誠出版)。
基本 光工学 2
英語、長文読解マスタープログラム
【最短翌日到着】
語学+参考書 The Spatial Economy: Cities Regions and International Trade (The MIT Press)
正午12時まで(日曜日は午前9時まで)の注文は当日発送(土日祝も発送)。語学+参考書 The Fama Portfolio: Selected Papers of Eugene F. Fama (Emersion: Emergent Village resources for communities of faith)。関東・関西・中部・中国・四国・九州地方は翌日お届け、東北地方・新潟県・北海道・沖縄県は翌々日にお届けします。日本基督教団年鑑 2013。
万有百科大事典 20
最新口腔外科学 第5版 Oral and Maxillofacial Surgery 榎本 昭二、 道 健一、 天笠 光雄; 小村 健
【インボイス制度対応済み】
腎移植のすべて 高橋 公太
当社ではインボイス制度に対応した適格請求書発行事業者番号(通称:T番号・登録番号)を印字した納品書(明細書)を商品に同梱してお送りしております。浜学園 小6 女子トップレベル 国語特訓問題集 第1〜3分冊 通年セット 2020 計3冊 020S2D。こちらをご利用いただくことで、税務申告時や確定申告時に消費税額控除を受けることが可能になります。希学園 小4 最高レベル演習 算数 オリジナルテキスト 第1〜4分冊 通年セット 2020 計4冊 ☆ 090R2D。
NeuroICUブック 黒田泰弘、 永山正雄、 横堀將司; 江川悟史
憲法 2 新版改訂 基本的人権 法律学全集 (4) 宮沢 俊義
ご満足のいく取引となるよう精一杯対応させていただきます。The Kelly Capital Growth Investment Criterion: Theory and Practice (World Scientific Handbook in Financial Economic Series, 3) [ハードカバー] Maclean, Leonard C.? Thorp, Edward O.; Ziemba, William T.。
プロフェッショナル腎臓病学 [単行本(ソフトカバー)] 南学 正臣
Principles of Neurobiology [ペーパーバック] Luo, Liqun
※下記に商品説明およびコンディション詳細、出荷予定・配送方法・お届けまでの期間について記載しています。鉄緑会 入試生物演習 【計11回分】 2023 伊藤正浩 ☆ 035S0D。ご確認の上ご購入ください。Electronic Imaging in Astronomy: Detectors and Instrumentation (Astronomy and Planetary Sciences) [ペーパーバック] McLean, Ian S.。
コンクリート標準示方書 規準編 2007年制定
CDリスニング音で知る改正刑事訴訟法条文 (<CD>)
■商品名■
小児神経学の進歩 第43集 日本小児神経学会教育委員会
Brock微生物学
近世の神社・門跡と朝廷 石津 裕之
鉄緑会 高1年 校内模試問題 第1/2回 2017年度 2017年8月/2018年2月実施 英語/数学 ☆ 015m0D
■出版社■
近世測量絵図のGIS分析: その地域的展開 平井 松午
オーム社
脳神経血管内治療のすべて: 最新症例から学ぶ
グノーブル 小6 GNO(グノ)ラーニング 春期/夏期/冬期/志望校特訓など 社会 通年セット 【計100回分】 2023 ★ ☆ 000L2D
■著者■
グノーブル 小6 GNO(グノ)ラーニング 春期/夏期/冬期/志望校特訓など 国語 通年セット 【計107回分】 2023★ ☆ 000L2D
Brock
皮膚科診療カラーアトラス大系 1 鈴木 啓之; 神崎 保
分子医科学実験プロトコ-ル: 分子生物学実験とその臨床応用 (細胞工学別冊) 東京大学医科学研究所学友会
■発行年■
許可抗告事件の実情 平成10~29年度 判例時報編集部
2003/04/15
日本評論社 数セミ・ブックス 第1〜13巻 一幾何学者の回想 等 1982 計13冊 矢野健太郎/細井勉/A・ヴェイユ他 ★ ☆ 000L6D
語学+参考書 Basic Number Theory (Grundlehren der mathematischen Wissenschaften)
■ISBN10■
分子進化と分子系統学
4274024881
カワラダデンチャ-システム臨床質疑応答集: “痛い”“噛めない”“外れる”総義歯救出大作戦 川原田幸三、 山口久和; 川原田美千代
四谷大塚 小6 学校別予習シリーズ 桜蔭への算数 第1〜14回 通年セット 計14冊 ☆ 065R2D
■ISBN13■
超アトラス眼瞼手術―眼科・形成外科の考えるポイント―
9784274024887
A Relativist's Toolkit: The Mathematics of Black-Hole Mechanics Poisson, Eric
集英社 - 集英社版・学習漫画 日本の歴史 1〜20巻 人物事典+出来事辞典セット
■コンディションランク■
鉄緑会2017年度 第1/2回 中3校内模試【成績資料と講評冊子付き】2017年8月/2018年2月実施英語/数学 ☆ 020m0D
可
5年でマスター 消化器標準手術?消化器外科専門医への道 改訂第2版 桑野 博行; 調 憲
語学+参考書 Modelling Pricing and Hedging Counterparty Credit Exposure: A Technical Guide (Springer Finance)
コンディションランク説明
漢文単語文例精解
ほぼ新品:未使用に近い状態の商品
運動器の計測線・計測値ハンドブック 紺野 愼一
非常に良い:傷や汚れが少なくきれいな状態の商品
健康な歯肉とブラッシング(全3冊セット) 丸森賢二
良い:多少の傷や汚れがあるが、概ね良好な状態の商品(中古品として並の状態の商品)
学研パーフェクトコース 参考書 中学5教科セット 新装版(中学3年間)
可:傷や汚れが目立つものの、使用には問題ない状態の商品
診療画像検査法X線撮影法
ボツリヌストキシンを効果的に使うために: 美容医療 新橋 武
■コンディション詳細■
Molecular Biology of the Cell [ハードカバー] s, Bruce
当商品はコンディション「可」の商品となります。最終値下げ 7冊セット(5冊+おまけ2冊)TOEIC 公式問題集。多少の書き込みが有る場合や使用感、傷み、汚れ、記名・押印の消し跡・切り取り跡、箱・カバー欠品などがある場合もございますが、使用には問題のない状態です。語学+参考書 Combo Split With My Keynote Online (Keynote 2)。水濡れ防止梱包の上、迅速丁寧に発送させていただきます。Gnoble グノーブル 小5 算数 GNO/グノラーニング 春/GW/夏/冬/T授業 通年セット/各種テスト付 2022 計101冊 ★ ☆ 000L2D。
医療経営の基本と実務―経済産業省サービス産業人材育成事業医療経営人材育成テキスト (下巻)【管理編】
学校事故: 判例ハンドブック 坂東 司朗; 羽成 守
FIRSTHAND SUCCESS GOLD : SB Helgesen, Marc、 Brown, Steve、 Kahny, Jim; Rost, Michael
■当社の出品一覧↓■
Nonlinear Oscillations, Dynamical Systems, and Bifurcations of Vector Fields (Applied Mathematical Sciences, 42)
#ブックスドリーム出品一覧
医学部川崎医科大学: 医学部医学科10年間集録 (2014年度) (私立大学別医学部入試問題の解き方と出題傾向の分析)
参考書・赤本・専門書・医学書、予備校テキスト・塾テキスト・教材を30万点以上出品しています。Gnoble グノーブル 小5 算数 基礎力テスト 2022年2〜12月/2023年1月号 通年セット 計12冊 ☆ 053M2D。
四谷大塚 小6 学校別予習シリーズ 桜蔭への社会 第1〜14回 通年セット 計14冊 ☆ 063R2D
京進TOPΣ 京都大学 新3年 京大現代文 テキスト通年セット 計8冊 湯木知史 ☆ 043M0D
※上記クリック後、「半角または全角スペース+検索したいワード」を追加することで、予備校名や出版社名、講師名等で絞れます。Learning Support Systems for Organizational Learning (Series on Innovative Intelligence) [ハードカバー] Hasebrook, Joachim P.; Maurer, Hermann A.。
SUCCESS(KAO) - 法政大学第二中学校 過去問 サクセス 合格レベル問題集1 2 3 4 5
例)
会社法計算書類の作成実務と記載事例 東陽監査法人
「#ブックスドリーム出品一覧駿台」
現代ドイツ文法 新装版/三修社/ゲルハルト・ヘルビヒ(単行本)
「#ブックスドリーム出品一覧旺文社」
Asymmetric Oxidation Reactions: A Practical Approach in Chemistry (The Practical Approach in Chemistry Series) Katsuki, Tsutomi
「#ブックスドリーム出品一覧四谷大塚小6算数」
細胞生物学・組織学の要点整理
民商事と交錯する経済犯罪 (3) 本江威憙
こぐま会ひとりでとっくん365日12点 テスト 4点 全16点セット 裁断済み
【発送予定日について】
鉄緑会 U4W2クラス 物理受験講座 入試物理演習 【計13回分】 梨井陽平 ☆ 025S0D
正午12時まで(日曜日は午前9時まで)のご注文は当日に発送いたします。数学C―数研版 (教科書ガイド)。正午12時(日曜日は午前9時)以降のご注文は翌日に発送いたします(土曜日・日曜日・祝日も発送しています)。中学受験 暗記カード【4年上 社会 全セット 社会 1-19回】組分けテスト対策。
赤松俊秀著作集 (1) (赤松俊秀著作集 第 1巻) [単行本] 赤松 俊秀
※土曜日・祝日も正午12時までのご注文は当日に発送いたします。Neck and Internal Organs (Thieme Atlas of Anatomy) Schuenke, Michael? Schulte, Erik? Schumacher, Udo; Rude, Juergen。
カラーアトラス 病理組織の見方と鑑別診断 第7版
※年末年始(12/31〜1/3)は除きます。Gnoble グノーブル 小5 理科 基礎力テスト 2022年3〜12月/2023年1月号 通年セット 計11冊 ☆ 047M2D。
希学園 小6 ベーシック理科 第1〜4分冊 問題編/解答編 テキスト通年セット 2023 計8冊 ☆ 060M2D
全国大学数学入試問題詳解国公立大学 平成26年度 聖文新社編集部
(例)
薬剤の母乳への移行 第3版 菅原 和信; 豊口 禎子
・月曜0時〜12時までのご注文:月曜日に発送
英和活用大辞典
・月曜12時〜24時までのご注文:火曜日に発送
代々木ゼミナール 代ゼミ ハイレベル世界史問題演習 テキスト通年セット 未使用品 2022 計2冊 佐藤幸夫 ☆ 014m0D
・土曜0時〜12時までのご注文:土曜日に発送
標準化学用語辞典[縮刷版]
・土曜12時〜24時のご注文:日曜日に発送
知っているようで知らない 新しい 糖尿病網膜症診療 石田 晋
・日曜0時〜9時までのご注文:日曜日に発送
専門医のための血液病学 鈴木 隆浩、 竹中 克斗; 池添 隆之
・日曜9時〜24時のご注文:月曜日に発送
【中古】 新版 合格英文150 2色版/ごま書房新社/鈴木友康
お受験 幼稚園受験 田園調布雙葉・雙葉小学校附属幼稚園 願書 面接例文 入試対策
【送付方法について】
【中古】日本語漢字入門〈タイ語版〉/国際交流基金 編
ネコポス、宅配便またはレターパックでの発送となります。現代の量子力学 (上・下・演習)3冊セット。
英語年鑑 2012年版/研究社/研究社(単行本)
希学園 小5 最高レベル演習 算数 オリジナルテキスト 第1〜4分冊 通年セット 2021 計4冊 ☆ 090R2D
東北地方・新潟県・北海道・沖縄県・離島以外は、発送翌日に到着します。伝承から科学へ 2。
JNCIS: Juniper Networks Certified Internet Specialist Study Guide: Exam JN0-303 Soricelli, Joseph M.
東北地方・新潟県・北海道・沖縄県・離島は、発送後2日での到着となります。今読むべきインパクトの高いインプラント80論文&88症例 一般社団法人日本インプラント臨床研究会。
カラー図説白癬
金属の疲労と破壊: 破面観察と破損解析 [単行本] Charlie R.Brooks、 Ashok Choudhury; 加納 誠
物質の構造: マクロ材料からナノ材料まで [単行本] S.M.Allen、 E.L.Thomas; 齋藤 秀俊
商品説明と著しく異なる点があった場合や異なる商品が届いた場合は、到着後30日間は無条件で着払いでご返品後に返金させていただきます。語学+参考書 Topological Data Analysis for Scientific Visualization (Mathematics and Visualization)。取引メッセージにてご連絡ください。ディズニー英語教材 トークアロング。
商品情報
ベストセラーランキングです
近くの売り場の商品
カスタマーレビュー
オススメ度 4.6点
現在、2896件のレビューが投稿されています。

![その他 LA VIE EN ROSE KAMIJO -20th ANNIVERSARY BEST- Grand Finale Zepp DiverCity Tokyo [DVD] 2zzhgl6](https://img.fril.jp/img/760203720/l/2567625800.jpg)